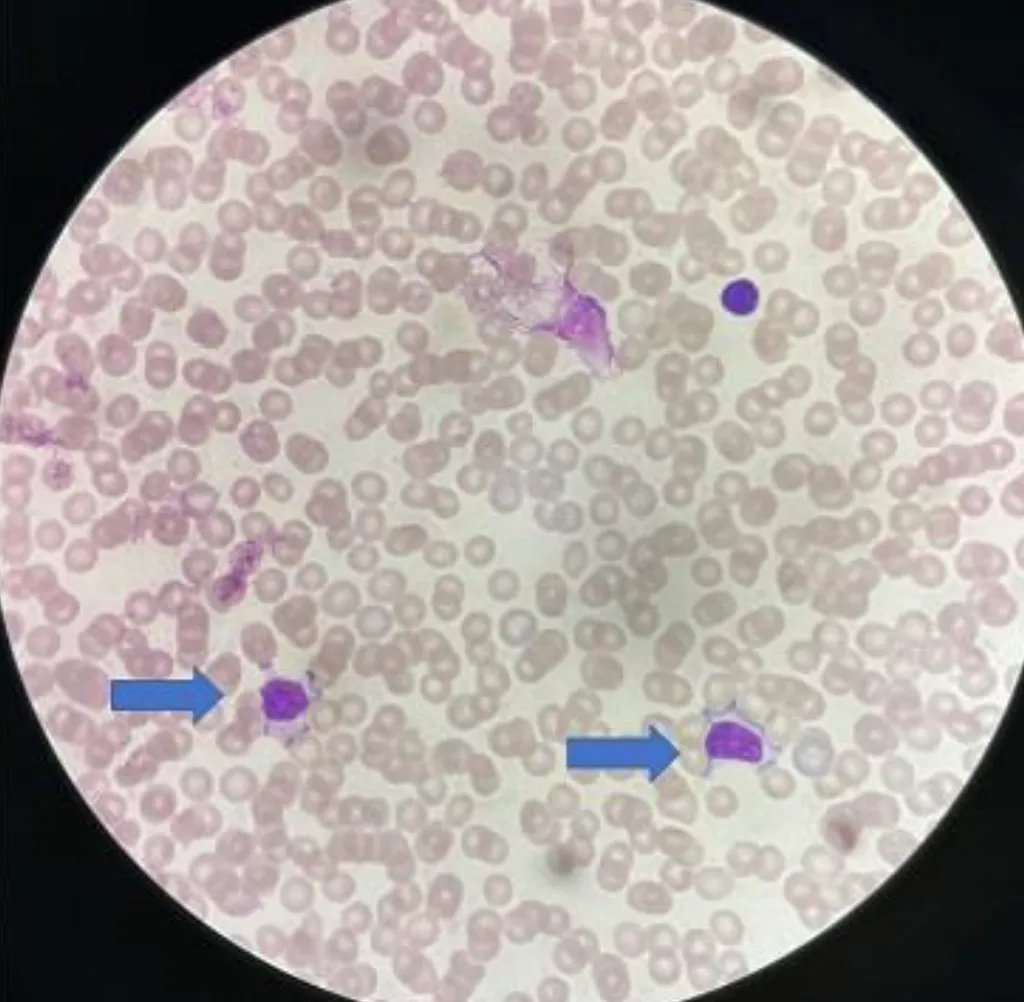

內分泌代謝1 / 47
【114-1 醫學(四) 第25題】14 歲女孩有無痛性的雙側甲狀腺腫大,合併心悸、體重減輕、月經不規則。實驗室檢查顯示,free T4 3.6 ng/dL(參考值 0.79~1.89)、TSH<0.03 mIU/L(參考值 0.5~5.5)。下列何者是最可能的診斷?
詳解
破題關鍵
甲狀腺功能亢進的典型症狀,加上雙側甲狀腺腫大,最符合葛雷夫氏病。
選項拆解
-A:正確。雙側無痛性甲狀腺腫大、心悸、體重減輕、月經不規則,加上 free T4 升高、TSH 降低,這些都是葛雷夫氏病(Graves disease)的典型表現。
內分泌代謝2 / 47
【114-1 醫學(四) 第63題】和壓力反應最有相關的內分泌系統,俗稱壓力賀爾蒙,下列何者為最相關?
詳解
破題關鍵
壓力賀爾蒙的代名詞就是皮質醇 (cortisol),而皮質醇的分泌主要由 HPA 軸調控。
選項拆解
-A:錯在性荷爾蒙系統主要與生殖和性徵有關,與壓力反應的直接關聯性較低。
-B:錯在腸胃系統的神經胜肽主要調控消化功能,與壓力反應的直接關聯性較低。
心臟血管學3 / 47
【114-1 醫學(四) 第6題】關於兒童心肌炎(myocarditis),下列敘述何者最不適當?
詳解
破題關鍵
兒童心肌炎的預後多樣,許多病例能完全康復,並非大多數會留下嚴重後遺症。
選項拆解
-A:正確。病毒感染是引起兒童心肌炎最常見的病因。
-B:正確。心肌炎的臨床表現範圍很廣,從輕微到嚴重都有,部分病例確實屬於輕症。
心臟血管學4 / 47
【114-1 醫學(四) 第7題】出生 2 天的女嬰發紺,被診斷為大血管轉位(d-transposition of the great arteries with intact ventricular septum)。下列何者之處置最不適當?
詳解
破題關鍵
大血管轉位合併完整心室中隔的嬰兒,嚴重發紺時可能需要氣管內管以穩定病情,避免放置是不適當的。
選項拆解
-A:正確。若兩心房間交通受限,心房造口術是改善血液混合、提高氧合的關鍵緊急處置。
心臟血管學5 / 47
【114-1 醫學(四) 第8題】關於各種先天性心臟病引起心臟衰竭的臨床症狀表現時機,下列何者最為適當?
詳解
破題關鍵
嚴重的心臟結構異常,特別是涉及瓣膜功能障礙的,可能在胎兒期就導致心臟衰竭。
選項拆解
-A:大型的心室中隔缺損(VSD):錯在通常出生後 4-6 週,當肺血管阻力下降後,才會因肺血流量過多而出現心臟衰竭症狀,出生一週內較不常見。
心臟血管學6 / 47
【114-1 醫學(四) 第22題】對於兒童氣胸發生後的治療方針,下列敘述何者最適當?
詳解
破題關鍵
小範圍的氣胸,身體有機會自行吸收,不一定需要立即侵入性治療。
選項拆解
-A:正確。輕至中度的氣胸,特別是小於 20% 的氣胸,如果病人症狀穩定,通常可以觀察,有機會在數天到一週內自行改善。
感染症7 / 47
【114-1 醫學(四) 第1題】下列有關自費疫苗接種建議之敘述,何者最不適當?
詳解
破題關鍵
結合型肺炎鏈球菌疫苗是專為嬰幼兒設計的。
選項拆解
-A:錯在「結合型疫苗不適用於 2 歲以下幼兒」。事實上,結合型肺炎鏈球菌疫苗(PCV)正是專為 2 歲以下嬰幼兒設計的,能有效誘導其免疫反應。多醣體疫苗(PPSV)才不適用於 2 歲以下幼兒。
感染症8 / 47
【114-1 醫學(四) 第9題】關於肝炎病毒潛伏期(incubation periods),下列敘述何者最適當?
詳解
破題關鍵
記住常見肝炎病毒的潛伏期範圍,A肝和E肝較短,B肝和C肝較長。
選項拆解
-A:正確。A型肝炎病毒的潛伏期範圍約 15-50 天,平均約 28-30 天,選項的 15-19 天雖然是範圍的下限,但相較其他選項是相對最接近的。
感染症9 / 47
【114-1 醫學(四) 第11題】3 歲男童無特殊病史,因高燒、倦怠(malaise)、陣發性腹痛、頻繁水瀉 2 天被送到急診。男童無嘔吐,無服用抗生素。身體診察顯示體溫 40.2℃、口腔黏膜乾、心搏快、腹部軟、沒有壓痛(tenderness)或反彈痛 (rebound tenderness)。觸診時,男童突然腹絞痛,接著排出含有血絲黏糊便。下列何者是最可能的致病菌?
詳解
破題關鍵
高燒、腹痛、水瀉後出現血絲黏糊便,且無抗生素使用史,指向侵入性細菌感染。
選項拆解
-A:錯在輪狀病毒 (Rotavirus) 引起的腸胃炎主要症狀是水瀉和嘔吐,通常不會有高燒和血便。
感染症10 / 47
【114-1 醫學(四) 第21題】關於小兒敗血症與敗血性休克的敘述,下列何者最適當?
詳解
破題關鍵
這題考的是小兒敗血症與敗血性休克的臨床判斷與處置原則。解題核心在於理解敗血症的定義、兒童敗血症的早期表現與休克的嚴重程度判斷。圖片與題目內容無直接關聯,請專注於文字敘述。
選項拆解
感染症11 / 47
【114-1 醫學(四) 第23題】2 歲女童,發燒、持續昏睡、呼吸喘及有肌躍型抽搐,身體診察有口腔潰瘍,手部、足部與臀部出現紅色丘疹及水泡。關於此病症的敘述,下列何者最不適當?
詳解
破題關鍵
腸病毒重症併發腦幹腦炎時,快速大量輸液可能加重心臟負荷,導致肺水腫。
選項拆解
-A:正確。肌躍型抽搐(myoclonic jerk)是腸病毒重症併發腦幹腦炎的典型前兆之一,表現為類似受到驚嚇的動作。
感染症12 / 47
【114-1 醫學(四) 第26題】2 歲男童發燒 5 天伴隨全身性瘀點(petechiae)而住院,同時有鼻塞及雙眼眼皮浮腫。身體診察發現頸部淋巴結腫大、扁桃腺有滲出物。抽血檢查:Hb 10 g/dL、WBC 18800/μL、atypical lymphocyte 16%、 platelet 20000/μL,GOT 194 IU/L、GPT 109 IU/L、CRP 0.5 mg/dL,EB VCA IgM>160.0 U/mL;血液塗片染色如圖所示。有關此疾病的敘述,下列何者最不適當?

詳解
破題關鍵
這題的解題核心在於判斷病患的臨床表現和檢驗結果是否符合 Epstein-Barr virus (EBV) 感染引起的傳染性單核球增多症 (infectious mononucleosis),並了解其標準治療原則。圖片中箭頭所指的細胞是診斷 EBV 感染的重要血液學特徵。
感染症13 / 47
【114-1 醫學(四) 第27題】關於活性減毒疫苗,下列敘述何者最不適當?
詳解
破題關鍵
B 型流行性腦脊髓炎疫苗不是活性減毒疫苗。
選項拆解
-A:錯在「B 型流行性腦脊髓炎疫苗都是活性減毒疫苗」。B 型流行性腦脊髓炎疫苗目前主要為不活化疫苗或重組疫苗,而非活性減毒疫苗。
-B:正確。活性減毒疫苗能模擬自然感染,因此通常能誘發長期且強烈的細胞免疫和體液免疫反應。
感染症14 / 47
【114-1 醫學(四) 第28題】關於麻疹腮腺炎德國麻疹混合疫苗(MMR 疫苗)接種及疑似麻疹個案接觸者暴露後預防建議措施的敘述,下列何者最不適當?
詳解
破題關鍵
免疫球蛋白會干擾疫苗效果,兩者不能同時或太接近施打。
選項拆解
-A:正確。對於未滿 1 歲的嬰兒,在暴露麻疹後 72 小時內,醫師會評估選擇接種 MMR 疫苗(6 個月以上)或肌肉注射麻疹免疫球蛋白(IMIG)進行預防。
感染症15 / 47
【114-1 醫學(四) 第37題】下列關於皮膚的病毒感染之敘述,何者錯誤?
詳解
破題關鍵
這題考的是常見皮膚病毒感染的基礎知識。解題核心在於辨別哪個敘述是絕對化且不符合醫學事實的。圖片顯示手掌有散在性紅疹,這類表現常見於某些病毒感染,例如手足口病,但與題目選項的正確性判斷無直接關聯。
選項拆解
感染症16 / 47
【114-1 醫學(四) 第42題】25 歲女性發現雙側腋下及腹股溝出現反覆發炎疼痛之結節並有膿樣的分泌物,經診斷為化膿性汗腺炎(hidradenitis suppurativa)。下列有關化膿性汗腺炎之敘述,何者錯誤?
詳解
破題關鍵
本題考驗對化膿性汗腺炎(hidradenitis suppurativa)的病因、診斷分期及治療原則的理解。關鍵在於辨識此疾病的發炎本質而非單純細菌感染,並了解其治療策略。圖片顯示了典型的化膿性汗腺炎病灶,有發炎結節、膿瘍和疤痕形成。
選項拆解
新生兒醫學17 / 47
【114-1 醫學(四) 第2題】下列有關母乳哺餵之敘述,何者最不適當?
詳解
破題關鍵
母乳性黃疸通常在出生後數週內消退,不會持續到六個月。
選項拆解
-A:正確。母乳哺育確實能減少寶寶過敏性疾病及成人期心血管疾病的發生率。
-B:正確。哺餵母乳的媽媽罹患乳癌及卵巢癌的機率較低。
新生兒醫學18 / 47
【114-1 醫學(四) 第3題】27 週出生的早產兒,開始餵食 12 天後,突然發生嗜睡、腹脹、含膽汁嘔吐、糞便帶血絲等症狀。其腹部 X 光檢查如下圖。發生此狀況時,下列何種處置最不適當?

詳解
破題關鍵
這題的解題核心是辨識早產兒腹部X光片上的典型病灶,並判斷在這種緊急情況下,哪些處置是必要的,哪些是禁忌。圖片中可見腸壁氣腫(pneumatosis intestinalis),這是壞死性腸炎(NEC)的經典影像學特徵。
選項拆解
新生兒醫學19 / 47
【114-1 醫學(四) 第5題】嬰兒出生後無法進食,持續使用靜脈營養(parenteral nutrition)。第 40 天後出現黃疸、糞便呈極淡黃色,實驗室檢查值:ALT(alanine aminotransferase)為 125 U/L,serum total bilirubin 為 12 mg/dL, conjugated bilirubin 為 5.6 mg/dL。下列何者最不可能是此嬰兒黃疸之原因?
詳解
破題關鍵
嬰兒有結合型高膽紅素血症和肝功能異常,吉伯特氏症候群只會導致非結合型高膽紅素血症。
選項拆解
-A:新生兒膽道閉鎖(biliary atresia):可能。這是新生兒結合型高膽紅素血症的常見原因,會導致糞便顏色變淡。
新生兒醫學20 / 47
【114-1 醫學(四) 第18題】關於剛出生健康足月新生兒的血液學變化,下列敘述何者最適當?
詳解
破題關鍵
新生兒的凝血系統尚未完全成熟,大多數凝血因子濃度較低,但第八因子是例外。
選項拆解
-A:錯在與學齡兒童相比,新生兒的紅血球體積較大 (MCV 較高),血紅素也較高。生理性貧血是指出生後 2-3 個月血紅素下降的現象,而非剛出生時。
新生兒醫學21 / 47
【114-1 醫學(四) 第24題】足月新生兒,出生體重 4250 公克。因為呼吸喘,入住新生兒病房。母親懷孕時有妊娠糖尿病,僅以飲食控制。出生 4 小時後,因為活動力不佳,檢查發現低血糖(血糖:39 mg/dL)。下列何種處置最不適當?
詳解
破題關鍵
新生兒低血糖時,應先穩定血糖,但同時也要採檢以找出原因。
選項拆解
-A:錯在「等到血糖>70 mg/dL,再抽血檢查低血糖的原因」。在給予葡萄糖治療前,應先抽血檢測血糖、胰島素、皮質醇等相關數值,以協助診斷低血糖的原因,而不是等到血糖恢復正常後再抽血。
新生兒醫學22 / 47
【114-1 醫學(四) 第75題】
出生 4 個月大的早產兒,因小腸壞死長期使用靜脈營養注射,因雙側踝關節變形所照的 X 光影像如圖示,下列何者為最常見的診斷?

詳解
破題關鍵
這道題的關鍵在於將早產兒、長期靜脈營養注射的病史,與 X 光影像中典型的生長板(growth plate)異常變化連結起來。
選項拆解
新生兒醫學23 / 47
【114-1 醫學(四) 第79題】滿 24 週之胎兒,預估體重 500 公克,因破水併子宮收縮,安胎無效,準備生產。胎兒父親要求放棄此胎兒, 出生後不要施予急救。下列何種做法最為適當?
詳解
破題關鍵
24 週胎兒已達可存活邊緣,涉及醫療倫理和家屬知情同意,應充分溝通預後和選項。
選項拆解
-A:錯誤。優生保健法主要規範人工流產的條件,不適用於已達可存活邊緣的胎兒出生後是否急救的決定。此時應著重於新生兒的權益和家屬的知情同意。
社會與發展24 / 47
【114-1 醫學(四) 第66題】有關偷竊癖(kleptomania),下列何者錯誤?
詳解
破題關鍵
偷竊癖 (kleptomania) 的關鍵特徵是「衝動性」和「非計畫性」,且偷竊物品通常無實際用途或價值。
選項拆解
-A:正確。偷竊癖患者在偷竊前常感到緊張或興奮,偷竊後則感到解脫或滿足。
社會與發展25 / 47
【114-1 醫學(四) 第72題】侵擾性情緒失調疾患(disruptive mood dysregulation disorder, DMDD)和對立性反叛疾患 (oppositional defiant disorder, ODD)之比較,下列敘述何者錯誤?
詳解
破題關鍵
侵擾性情緒失調疾患 (DMDD) 的核心是「嚴重且持續的易怒」和「頻繁的嚴重發脾氣」,而對立性反叛疾患 (ODD) 的核心是「對立、反叛、不服從」。
選項拆解
社會與發展26 / 47
【114-1 醫學(四) 第76題】7 歲男童因異物梗塞無法出聲時,下列處置何者最適當?
詳解
破題關鍵
本題考驗對兒童異物梗塞(choking)急救流程的理解。當兒童因異物梗塞而無法出聲時,表示氣道完全或嚴重阻塞,此時最關鍵的處置是立即執行哈姆立克法(Heimlich maneuver)。題目附圖與本題無關,請勿受其干擾。
選項拆解
社會與發展27 / 47
【114-1 醫學(四) 第77題】有關卡西酮(cathinone)類物質的濫用敘述,下列何者最適當?
詳解
破題關鍵
卡西酮類物質 (cathinones) 是一種興奮劑,其作用機轉類似安非他命。
選項拆解
-A:錯誤。卡西酮類物質的化學結構類似安非他命 (amphetamines),而非愷他命 (ketamines)。愷他命是一種解離性麻醉劑。
社會與發展28 / 47
【114-1 醫學(四) 第80題】10 歲的小女孩有一個罹患急性淋巴性白血病的 12 歲姐姐。她與姐姐 HLA 完全相符,因此在 2 年前是姐姐接受骨髓移植的最佳骨髓捐贈者。2 年後姐姐白血病復發,醫師與家屬決定再拚一次骨髓移植。所以這個 10 歲的小女孩入院準備抽取骨髓。她卻在抽骨髓的當天早上逃離了醫院,隨後雖然找到了她,但抽取骨髓程序只好延後。下列做法何者最為適當?
詳解
破題關鍵
兒童捐贈骨髓涉及倫理和法律問題,特別是當兒童表達不願意時,必須尊重其意願並提供支持。
選項拆解
-A:錯誤。即使父母同意,兒童作為捐贈者,其意願也必須被尊重。特別是當兒童表達不願意時,不能僅憑父母同意就強制執行。
神經學29 / 47
【114-1 醫學(四) 第29題】有關腦性麻痺的敘述,下列何者最不適當?
詳解
破題關鍵
腦性麻痺的成因很多,新生兒窒息只是其中一小部分,並非主要原因。
選項拆解
-A:正確。腦室旁白質軟化 (PVL) 是早產兒腦性麻痺的主要病灶。
神經學30 / 47
【114-1 醫學(四) 第49題】對於不是重積癲癇(status epilepticus)的一般癲癇病人,下列抗癲癇藥物的使用,何者錯誤?
詳解
破題關鍵
一般癲癇治療強調逐步調整藥物劑量,以兼顧療效與副作用,與重積癲癇的緊急處理不同。
選項拆解
-A:正確。起始治療應根據癲癇的類型(如局部性發作、全面性發作)選擇最適合的單一藥物,以達到最佳療效並減少副作用。
神經學31 / 47
【114-1 醫學(四) 第52題】有關阿茲海默氏病(Alzheimer disease),下列敘述何者錯誤?
詳解
破題關鍵
阿茲海默氏病 (Alzheimer disease) 的家族性基因突變通常是顯性遺傳。
選項拆解
-A:正確。阿茲海默氏病是全球最常見的失智症類型,佔所有失智症案例的 60-80%。
神經學32 / 47
【114-1 醫學(四) 第58題】關於急性瀰漫性腦脊髓炎(acute disseminated encephalomyelitis, ADEM)的敘述,下列何者錯誤?
詳解
破題關鍵
急性瀰漫性腦脊髓炎 (ADEM) 的核心特徵是「單相性」病程,通常不會復發。
選項拆解
-A:正確。ADEM 是一種感染後或疫苗接種後的免疫反應,因此常發生在病毒或細菌感染後。
-B:正確。偶爾在疫苗接種後發生,這也是其免疫介導機轉的表現。
神經學33 / 47
【114-1 醫學(四) 第64題】有關群纖維肌痛(fibromyalgia)症候群有關的藥物治療,下列何者最不適當?
詳解
破題關鍵
纖維肌痛症 (fibromyalgia) 的治療強調多模式,且應避免長期使用成癮性藥物。
選項拆解
-A:錯誤。鴉片類藥物 (narcotics) 因其成癮性、副作用和長期療效不佳,不被推薦為纖維肌痛症的首選治療。
腎臟泌尿學34 / 47
【114-1 醫學(四) 第12題】關於自體顯性多囊腎(autosomal dominant polycystic kidney disease, ADPKD)及自體隱性多囊腎 (autosomal recessive polycystic kidney disease, ARPKD),下列敘述何者最不適當?
詳解
破題關鍵
記住 ADPKD 最常見的基因缺陷位置在第 16 對和第 4 對染色體。
選項拆解
-A:正確。ADPKD 的囊泡表現確實可見於肝臟、脾臟、胰臟與女性卵巢等腎外器官。
腎臟泌尿學35 / 47
【114-1 醫學(四) 第13題】關於急性鏈球菌感染後腎炎(acute poststreptococcal glomerulonephritis)的描述,下列何者最為適當?
詳解
破題關鍵
急性鏈球菌感染後腎炎 (APSGN) 的發生是免疫反應,而非細菌本身持續存在。
選項拆解
-A:錯在 APSGN 最常發生於 6-10 歲的學齡兒童,3 歲以下的孩童較少見。
腎臟泌尿學36 / 47
【114-1 醫學(四) 第14題】
5 歲女童高燒 3 日及膿尿(pyuria ; WBC 100~150/HPF),住院接受抗生素治療。經投與經驗性抗生素治療 3 日後,高燒並沒有改善。腹部電腦斷層(有注射顯影劑)檢查顯示如圖,女童最可能的診斷為:

詳解
破題關鍵
這張腹部電腦斷層影像顯示腎臟有不均勻的顯影,特別是右腎出現多處條紋狀或楔形低密度病灶,這是急性大葉性腎盂腎炎的典型表現。
選項拆解
腎臟泌尿學37 / 47
【114-1 醫學(四) 第15題】關於過敏性紫斑症(Henoch-Schönlein purpura),下列敘述何者最為適當?
詳解
破題關鍵
過敏性紫斑症 (HSP) 的核心病理特徵是 IgA 介導的小血管炎。
選項拆解
-A:錯在紫斑 (purpura) 主要出現在下肢及臀部,而非上肢及軀幹。這是 HSP 的典型分佈。
血液腫瘤學38 / 47
【114-1 醫學(四) 第4題】剛出生新生兒之血紅素(hemoglobin)為 9.7 g/dL,血球容積比(hematocrit)為 30%,平均紅血球體積 (mean corpuscular volume, MCV)為 80 fL,由此檢驗值可推測此新生兒最有可能的診斷為何?
詳解
破題關鍵
新生兒出現小球性貧血,最常見且需考慮的診斷是 α 型地中海型貧血。
選項拆解
-A:缺鐵性貧血(iron deficiency anemia):錯在新生兒通常有足夠的鐵儲存,出生時即有嚴重缺鐵性貧血較不常見。
血液腫瘤學39 / 47
【114-1 醫學(四) 第10題】足月新生男嬰,出生體重 3 公斤,全母乳哺餵,出生後 6 小時開始出現黃疸。身體診察顯示鞏膜與皮膚黃疸。下列何項檢驗結果最可以支持男嬰的黃疸是溶血造成的?
詳解
破題關鍵
溶血性黃疸的關鍵證據是紅血球被破壞的直接證明。
選項拆解
-A:錯在直接型膽紅素 (direct bilirubin) 濃度上升通常表示膽汁鬱積 (cholestasis) 或肝細胞損傷,而不是溶血。溶血主要造成未結合型膽紅素上升。
血液腫瘤學40 / 47
【114-1 醫學(四) 第16題】有關兒童特發性關節炎(juvenile idiopathic arthritis),下列敘述何者最不適當?
詳解
破題關鍵
Omalizumab 是治療氣喘和慢性蕁麻疹的生物製劑,而非兒童特發性關節炎 (JIA)。
選項拆解
-A:正確。兒童特發性關節炎的診斷標準之一是發病年齡在 16 歲以下,且關節腫痛持續至少 6 週以上。
-B:正確。兒童特發性關節炎是兒童時期最常見的慢性風濕性疾病。
血液腫瘤學41 / 47
【114-1 醫學(四) 第17題】有關慢性蕁麻疹,下列敘述何者最適當?
詳解
破題關鍵
慢性蕁麻疹常與自體免疫疾病相關。
選項拆解
-A:錯在慢性蕁麻疹是指病程反覆發作 6 週以上,而非 14 天以上。14 天屬於急性蕁麻疹的範疇。
血液腫瘤學42 / 47
【114-1 醫學(四) 第19題】關於兒童癌症,下列敘述何者最不適當?
詳解
破題關鍵
兒童癌症大部分是偶發的,只有少數才跟遺傳有關。
選項拆解
-A:錯在「大部分(90%以上)都與先天性的遺傳疾病有關」。實際上,大部分兒童癌症是偶發性的,只有少數與遺傳有關。
-B:正確。白血病(leukemia)確實是臺灣和美國最常見的兒童癌症類別。
血液腫瘤學43 / 47
【114-1 醫學(四) 第20題】3 歲男童因發燒 1 週合併輕度貧血,做骨髓抽吸抹片檢查時發現多處細胞叢集(clumps)形成薔薇狀構造 (rosette formation),並圍繞著一些纖維狀物質。下列何者為最有可能的診斷?

詳解
破題關鍵
解題核心在於辨識骨髓抹片中特有的「薔薇狀構造」和「纖維狀物質」,這些是神經母細胞瘤轉移到骨髓的經典表現。圖片中可清楚看到一群群深紫色、圓形的小細胞聚集成團,有些呈現環狀排列,周圍有淡淡的粉紅色纖維狀基質。
選項拆解
醫學遺傳學44 / 47
【114-1 醫學(四) 第31題】關於 Wilson disease 的敘述,下列何者最不適當?
詳解
破題關鍵
威爾森氏症 (Wilson disease) 在年輕患者身上,肝臟症狀通常比神經症狀更早出現。
選項拆解
醫學遺傳學45 / 47
【114-1 醫學(四) 第33題】下列那一個狀況最不需要接受遺傳諮詢?
詳解
破題關鍵
遺傳諮詢主要針對有潛在遺傳風險或家族史的狀況。
選項拆解
-A:正確。年齡 35 歲以上的懷孕婦女,胎兒罹患染色體異常(如唐氏症)的風險增加,因此需要遺傳諮詢。
-B:正確。上一胎為先天性異常孩子的父母,可能存在遺傳因素,需要評估下一胎的復發風險。
醫學遺傳學46 / 47
【114-1 醫學(四) 第39題】某些遺傳性症候群的患者由於先天性基因的缺失,往往造成其皮膚發生鱗狀上皮細胞癌的機率較常人高。這些症候群不包括下列何者?
詳解
破題關鍵
史特基–韋伯氏症候群 (Sturge-Weber syndrome) 主要與血管畸形有關,而非皮膚癌風險增加。
選項拆解
醫學遺傳學47 / 47
【114-1 醫學(四) 第43題】下列何種疾病之遺傳模式是體染色體隱性遺傳(autosomal recessive)?
詳解
破題關鍵
這題考的是常見遺傳疾病的遺傳模式。
選項拆解
-A:錯在「第一型神經纖維瘤病 (neurofibromatosis type I)」。此為體染色體顯性遺傳疾病。
-B:錯在「結節性硬化症 (tuberous sclerosis)」。此為體染色體顯性遺傳疾病。